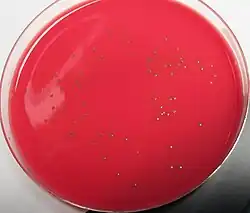

Listeria monocytogenes
| Listeria monocytogenes | ||||||||||||
|---|---|---|---|---|---|---|---|---|---|---|---|---|
Listeria monocytogenes | ||||||||||||
| Systematik | ||||||||||||
| ||||||||||||
| Wissenschaftlicher Name | ||||||||||||
| Listeria monocytogenes | ||||||||||||
| (Murray et al. 1926) Pirie 1940 |
Listeria monocytogenes ist ein nicht-sporenbildendes, grampositives, stäbchenförmiges, fakultativ-anaerobes und aufgrund von Flagellen bewegliches Bakterium (polare oder peritriche Begeißelung). Benannt wurde es nach dem englischen Chirurgen Joseph Lister sowie der häufig als Auswirkung einer Infektion auftretenden Monozytose, einer Vermehrung der Monozyten im Blut. Es ist in der Regel pathogen und verursacht eine Reihe von Erkrankungen beim Menschen und bei Tieren, die als Listeriose bezeichnet werden. Der häufigste Infektionsweg ist die Aufnahme über verunreinigte Lebensmittel.
Eigenschaften
Verbreitung
Listeria monocytogenes ist nicht auf bestimmte Wirtsorganismen oder Lebensräume beschränkt und gilt als ubiquitär verbreitet. Es wurde in einer Reihe von Wild- und Haustieren gefunden, darunter mindestens 37 Säugetierarten, mindestens 17 Vogelarten und vereinzelt auch Fischen und Schalentieren. Wahrscheinlich sind etwa ein bis zehn Prozent aller Menschen ebenfalls infiziert und scheiden den Erreger über den Stuhl aus. Darüber hinaus ist Listeria monocytogenes auch im Boden, in Gewässern, auf Pflanzen und in anderen natürlichen Lebensräumen nachweisbar und in der Lage, auf vielen verschiedenen Oberflächen Biofilme auszubilden.
Morphologie und Physiologie
Eine Listeria-monocytogenes-Zelle hat einen Durchmesser von 0,4 bis 0,5 Mikrometern und eine Länge von 0,5 bis 2,0 Mikrometern. Sie tritt entweder einzeln oder in Form von V- oder Y-förmigen Ketten auf und ist Katalase-positiv sowie Indol- und Oxidase-negativ. Darüber hinaus hydrolysiert sie keinen Harnstoff und ist kein Nitratreduzierer. Auf Kulturplatten bildet Listeria monocytogenes bis zu einem Millimeter große runde, blaugraue und durchscheinende Kolonien. Die Morphologie ist ähnlich derjenigen von Streptococcus agalactiae,[1] mit dieser Art können die Kolonien auch verwechselt werden (ebenfalls große, runde, graue Kolonien mit zarter β-Hämolyse auf Columbia-Blutagar).
Obwohl Listeria monocytogenes keine Sporen bildet, ist das Bakterium außergewöhnlich widerstandsfähig gegenüber Trockenheit, Kälte, höheren Temperaturen sowie einer hohen Salzkonzentration und einem gemäßigt sauren oder basischen pH-Wert von 4,4 bis 9,8 im Umgebungsmedium. Das Temperaturoptimum für das Wachstum liegt bei 30 bis 37 Grad Celsius. Aber auch bei Temperaturen von vier bis acht Grad Celsius, wie sie typischerweise in Kühlschränken vorliegen, ist Listeria monocytogenes zu begrenztem Wachstum fähig. Durch Temperaturen, die beispielsweise beim Kochen, Braten, Sterilisieren und Pasteurisieren auftreten, wird das Bakterium sicher abgetötet.
Nachweis

Die am häufigsten verwendete Methode zur Bestimmung von Listeria monocytogenes ist eine Anreicherungskultur über 24 bis 48 Stunden, gefolgt von Agglutinationstests mit spezifischen Antikörpern. Auch ein Nachweis von bestimmten DNA-Abschnitten mit Hilfe der Polymerase-Kettenreaktion (PCR) und der Hybridisierung an spezifische DNA-Sonden ist möglich. Als Alternative zu den immunologischen und den molekularbiologischen Methoden kann auch eine Bestimmung über biochemische Tests zum Nachweis bestimmter Enzymaktivitäten erfolgen. Diese Nachweismethode ist jedoch sehr zeitaufwändig.
Genom
Die Genome der zwei Stämme Listeria monocytogenes EGD-e (Serotyp 1 / 2a) und Listeria innocua CLIP 11262 (serotype 6a) wurden mittels Shotgun Sequencing vollständig sequenziert.[2] Listeria monocytogenes EGD-e besitzt ein zirkuläres Chromosom mit 2.944.528 Basenpaaren und kein Plasmid. Der GC-Gehalt liegt bei 39 Prozent, die Anzahl der proteincodierenden Gene beträgt 2853. Bei der Sequenzierung wurde festgestellt, dass die Funktionen von etwa 35,3 Prozent der Gene nicht vorhersagbar ist. Das Genom von Listeria monocytogenes EGD-e codiert mehrere Invasionsproteine. Die codierten Proteine weisen eine starke Ähnlichkeit mit denen von Bacillus subtilis auf. Beim Vergleich zwischen Listeria monocytogenes EGD-e und Listeria innocua CLIP 11262 fanden sich 270 (9,5 Prozent) Gene, die spezifisch für Listeria monocytogenes EGD-e waren, und 149 (fünf Prozent) für Listeria innocua spezifische Gene. Die DNA-Sequenzanalyse zeigte außerdem, dass eine enge Beziehung zwischen Listeria monocytogenes und Bacillus subtilis besteht und beide einen gemeinsamen Vorfahren haben. Der Gentransfer durch Transformation ist für die meisten Genomunterschiede zwischen beiden Spezies verantwortlich.
Pathogenität
Erkrankungsbilder
Listeria monocytogenes ist ein fakultativ pathogener Erreger. Infektionen verlaufen in den meisten Fällen klinisch inapparent, also ohne erkennbare Symptome. Begünstigende Faktoren für Erkrankungen sind eine Schwangerschaft, eine Nahrungsumstellung sowie das gleichzeitige Vorliegen von viralen oder parasitären Infektionen. Das von den Bakterien produzierte Toxin Listeriolysin O (LLO), das mit einer Kultur auf Blutagar nachgewiesen werden kann, spielt hinsichtlich der Pathogenität eine wesentliche Rolle. Das zugehörige Gen hlyA gilt als wichtigster Marker der Pathogenität von Listeria monocytogenes. Im Falle einer klinischen Manifestation ähneln sich die Erkrankungsbilder bei Menschen und Tieren. Eine Infektion mit Listerien wird Listeriose genannt. Sie hat je nach Region und Hygienestandards eine Inzidenz von zwei bis 15 Fällen pro einer Million Menschen pro Jahr und verläuft bei Menschen mit einem intakten Immunsystem in der Regel ohne oder nur mit vergleichsweise leichten Symptomen im Magen-Darm-Bereich wie Übelkeit, Erbrechen und Durchfall. Bei den meisten Patienten sind dies die einzigen Auswirkungen einer Infektion.
Bei Patienten mit Immunschwäche kann es hingegen zusätzlich je nach Infektionsort zu Lymphknotenschwellungen und zu Entzündungen am Auge kommen, die als Keratitis beziehungsweise Uveitis bezeichnet werden. Weitere mögliche Entzündungsorte sind Hals und Rachen, die Harnblase und das Nierenbecken. In einigen Fällen, vor allem bei älteren Menschen, ist auch eine Entzündung des Gehirns (Enzephalitis) oder der Hirnhäute (Meningitis) möglich, deren Sterblichkeit jeweils bis zu 70 Prozent betragen kann. Den genannten Erkrankungen geht meist eine Fieberphase mit influenzaähnlichen Symptomen voraus. Infektionen der Geschlechtsorgane bei schwangeren Frauen können zu Fehl- und Totgeburten führen, ebenso wie zu Blutvergiftung, Schwellungen der Leber und Milz, Atemproblemen sowie Entwicklungsverzögerungen bei Neugeborenen. Listeriose bei Neugeborenen, die eine hohe Sterblichkeit aufweist, sowie ein Nachweis des Erregers in Blut und Liquor cerebrospinalis eines Patienten sind in Deutschland meldepflichtig.
Für Listeria monocytogenes sind 13 O-antigenetische Muster bekannt. Hinsicht der Virulenzintensität wird Listeria monocytogenes in drei Kategorien eingeteilt. Zu den Erregern der Linie I mit der höchsten Pathogenität, die mit 98 Prozent am häufigsten epidemische Erkrankungen verursachen, gehören die Serotypen 1/2b, 3b, 4b und 4e. Dabei ist Serotyp 4b am deutlichsten virulent und führt mit 33 bis 50 Prozent am häufigsten zur Listeriose. Die Linie II beinhaltet die Serotypen 1/2a, 1/2c, 3a und 3c, die ein dazwischenliegendes pathogenes Potential besitzen und sporadische Erkrankungen hervorrufen. Zur Linie III gehören die Serotype 4a und 4c mit einer niedrigen Pathogenität.
Infektionswege und Behandlung
Die Übertragung von Listeria monocytogenes erfolgt durch direkten Kontakt mit infizierten Tieren sowie über verunreinigte Lebensmittel, vor allem Milchprodukte, Speiseeis, unbehandeltes Obst und Gemüse sowie Produkte aus rohem Fleisch. Für die Ausbreitung im Körper und das Erreichen bestimmter Orte wie dem Gehirn und des Fötus bei Schwangeren ist die Aufnahme in Phagocyten und deren Transport mit dem Blutstrom von wesentlicher Bedeutung. Die Inkubationszeit bis zum Auftreten von Symptomen im Magen-Darm-Bereich beträgt mindestens zwölf Stunden und für Symptome an anderen Körperorten mehrere Tage bis Wochen.
In einer bemerkenswerten Studie an Meerschweinchen wiesen Melton-Witt und andere nach, dass selbst bei asymptomatischen Infektionen eine Besiedlung der Leber und Reservoirbildung in den Microvilli mit dauernder Reinfektion der Peyer-Plaques stattfinden kann.[3]
Eine Behandlung von Infektionen mit Listeria monocytogenes ist mit verschiedenen Antibiotika möglich. Als Mittel der Wahl gilt das β-Lactam-Antibiotikum Ampicillin in hoher Dosierung, gegebenenfalls in Kombination mit einem Aminoglykosid. Als Alternative kommt Cotrimoxazol in Betracht.[1] Eine natürliche Resistenz besteht gegenüber Cephalosporinen.[4] Für die Prophylaxe sind vor allem eine ordnungsgemäße Verarbeitung, Zubereitung und Lagerung von Lebensmitteln, insbesondere ein ausreichendes Erhitzen, sowie entsprechende Hygienemaßnahmen notwendig.
Bekanntgewordene Fälle beim Menschen
Der erste identifizierte Fall einer Infektion im Menschen stammt aus dem Jahr 1929. Bis zu den 1970er Jahren galt Listeria monocytogenes vorwiegend als Problem bei der landwirtschaftlichen Haltung von Nutztieren, bei denen es vor allem Enzephalitiden und Fehlgeburten verursachte. Mit dem Beginn der 1980er Jahre gewann das Bakterium jedoch zunehmend an Bedeutung als Krankheitserreger beim Menschen. Die erste dokumentierte Epidemie fand 1981 in Halifax (Kanada) statt, mit 41 Erkrankten und 17 Todesfällen. Weitere umfangreiche Epidemien gab es von 1983 bis 1988 in der Schweiz mit 122 Erkrankten und 33 Todesfällen (siehe Abschnitt Listerien-Epidemie der 1980er-Jahre im Artikel Vacherin Mont-d’Or),[5] 1985 in Kalifornien mit 142 Erkrankten und 48 Todesfällen, von 1989 bis 1990 in Großbritannien mit 300 Erkrankten (ohne Todesfall), 1992 in Frankreich mit 279 Erkrankten und 85 Todesfällen, 2000 in Frankreich mit 32 Erkrankten und 10 Todesfällen[6] und von 2018 bis 2020 in der Schweiz mit 34 Erkrankten und 10 Todesfällen.[7] Laut AGES besteht der Verdacht eines Ausbruchs in Österreich im Zeitraum 2020–2022 mit möglicherweise 3 Todesfällen.[8]
Lebensmittelsicherheit
Obwohl Listerien fast überall sind, erscheint die Zahl der nachgewiesenen Erkrankungen überraschend niedrig (für 2018 in Deutschland 698 Meldungen[9]). Das könnte mit der schwierigen Nachweisbarkeit der Listeriose und daran liegen, dass Erkrankung erst Wochen später mit unspezifischen Symptomen wie Fieber und Durchfall ausbrechen kann. Da Listeria monocytogenes im Bereich der Lebensmittelinfektionen zu den häufigen und gefährlichen Erregern zählen, gelten nach dem Recht der EU für Lebensmittelunternehmer, die verzehrfertige Lebensmittel herstellen, welche wie etwa Käse oder roher Schinken eine durch Listeria monocytogenes verursachtes Risiko für die öffentliche Gesundheit bergen können, besondere Anforderungen an ihre Hygienemaßnahmen zur Sicherstellung akzeptabler Erzeugnisse:[10] So haben sie planmäßig Proben aus den Verarbeitungsbereichen und Ausrüstungsgegenständen zu nehmen und auf diesen Erreger untersuchen zu lassen. Als Lebensmittelsicherheitskriterium und zugleich Grenzwert für die Verkehrsfähigkeit des Lebensmittels ist dabei ein Messwert von höchstens 100 koloniebildenden Einheiten pro Gramm bestimmt, der während der gesamten angegebenen Haltbarkeitsdauer zu gewährleisten ist. Bei Säuglingsnahrung allerdings dürfen keine Listerien nachweisbar sein und bei mikrobiologisch sensiblen Lebensmitteln zumindest beim Hersteller keine. Über diesen Werten gilt ein verzehrfertiges, also üblicherweise vor der Aufnahme nicht mehr erhitztes Lebensmittel als unsicher, so dass die gesamte Partie dieses Lebensmittels vom Markt zu nehmen ist und veräußerte Erzeugnisse zurückzurufen sind.[11] Wer solche Lebensmittel dennoch herstellt oder in Verkehr bringt, macht sich in Deutschland auch bei Fahrlässigkeit strafbar.[12]
Meldepflicht
In Deutschland ist der direkte Nachweis von Listeria monocytogenes namentlich meldepflichtig nach § 7 des Infektionsschutzgesetzes, sofern der Nachweis auf eine akute Infektion hinweist und es sich um einen direkte[n] Nachweis aus Blut, Liquor oder anderen normalerweise sterilen Substraten sowie aus Abstrichen von Neugeborenen handelt. Die Meldepflicht betrifft in erster Linie die Leitungen von Laboren (§ 8 IfSG).
In der Schweiz ist der positive und negative laboranalytische Befund zu Listeria monocytogene für Laboratorien meldepflichtig und zwar nach dem Epidemiengesetz (EpG) in Verbindung mit der Epidemienverordnung und Anhang 3 der Verordnung des EDI über die Meldung von Beobachtungen übertragbarer Krankheiten des Menschen.
Historische Informationen
Im Jahre 1911 berichtete Gustav Hülphers in Schweden über die Anwesenheit von grampositiven stabförmigen Mikroorganismen in der Leber von Kaninchen und nannte sie Bacillus hepatis. Listeria monocytogenes wurde erstmals 1923 beschrieben und drei Jahre später von Everitt George Dunne Murray aus dem Blut von infizierten Kaninchen, die eine deutliche Monozytenvermehrung im Blutbild aufwiesen, isoliert und dokumentiert. Während der Untersuchung einer Epidemie bei Kaninchen und Meerschweinchen wurden auch Versuchstiere mit dem Erreger infiziert. Die Infektion induzierte eine ausgeprägte Monozytose und führte zu Läsionen in der Lunge. Daher erhielt der Erreger den Namen Bacterium monocytogenes. 1940 isolierte J. H. Harvey Pirie in Südafrika einen kleinen grampositiven Bazillus aus der Leber von afrikanischen Wüstenrennmäusen, den er zu Ehren von Lord Lister, dem Vater der Antiseptik, Listerella hepatolitica nannte. Der Hygieniker und Mikrobiologe Heinz Seeliger klärte 1952 die Ätiologie der Granulomatosis infantiseptica, der konnatalen Listeriose, auf. Zuvor war diese von Jürgen Potel als tödliche, septische, granulomatöse Infektion bei Neugeborenen beschrieben und als von einem eigenen Erreger (Corynebacterium infantisepticum) verursacht angenommen worden.[13]
Einzelnachweise
- ↑ a b Listeriose. RKI-Ratgeber für Ärzte. Robert Koch-Institut, 3. August 2012, abgerufen am 17. Februar 2013.
- ↑ P. Glaser et al.: Comparative Genomics of Listeria Species ( vom 24. Oktober 2007 im Internet Archive) (PDF; 526 kB) In: Science. Jahrgang 294, Ausgabe 5543 vom 26. Oktober 2001, S. 849–852
- ↑ J. A. Melton-Witt, S. M. Rafelski u. a.: Oral infection with signature-tagged Listeria monocytogenes reveals organ-specific growth and dissemination routes in guinea pigs. In: Infection and Immunity. Band 80, Nr. 2, Februar 2012, ISSN 1098-5522, S. 720–732, doi:10.1128/IAI.05958-11, PMID 22083714, PMC 3264322 (freier Volltext) – (englisch).
- ↑ R. Leclercq et al.: EUCAST expert rules in antimicrobial susceptibility testing. In: Clinical Microbiology and Infection. Band 19, Nr. 2. Wiley-Blackwell, 2013, ISSN 1469-0691, S. 141–160, doi:10.1111/j.1469-0691.2011.03703.x, PMID 22117544 (englisch, wiley.com [abgerufen am 17. Februar 2013]).
- ↑ Sabine Kuster: So viele Todesfälle wegen Listerien gab es seit dem ersten Ausbruch in den 80er-Jahren nicht mehr. Aargauer Zeitung, 27. August 2020, abgerufen am 26. März 2021.
- ↑ Johannes Kämer, Alexander Prange: Lebensmittelmikrobiologie. Hrsg.: UTB. 4. Auflage. Nr. 1421. Eugen Ulmer KG, Stuttgart 2017, ISBN 978-3-8252-4658-7, S. 400.
- ↑ Tim Wirth: Der tödliche Käse aus der Urschweiz. In: Tages-Anzeiger, 28. August 2020 (Archiv).
- ↑ Rückruf von Käserei: Verdacht auf Listerien-Tote In: noe.orf.at, 16. September 2022.
- ↑ RKI: Epidemiologisches Bulletin Nr. 3/2020, vom 16. Januar 2020, S. 18, für 2019: 591 Fälle, im Vergleich dazu 13636 Salmonellose-Fälle
- ↑ dazu und zu folgendem: Art. 3 Abs. 1, Art. 5 Abs. 2 der Verordnung (EG) Nr. 2073/2005 der Kommission vom 15. November 2005 über mikrobiologische Kriterien für Lebensmittel in der konsolidierten Fassung vom 28. Februar 2019, in ihrem Anhang 1 Ziff.1.1-1.3 zu Listeria
- ↑ Art. 7 Verordnung (EG) 2073/2005 „Unbefriedigende Ergebnisse“
- ↑ § 58 Abs. 2 und § 5 Abs. 1 LFGB in Verbindung mit Art. 14 Verordnung (EG) Nr. 178/2002
- ↑ Heinz P. R. Seeliger: 50 Jahre erlebte Mikrobiologie und Hygiene. In: Würzburger medizinhistorische Mitteilungen. Band 9, 1991, S. 207–216; hier: S. 209.
Literatur
- M. Hamon, H. Bierne, P. Cossart: Listeria monocytogenes. A Multifaceted Model. In: Nature Reviews. Microbiology. Band 4, Nr. 6. Nature Publishing Group, 2006, ISSN 1740-1526, S. 423–434 (englisch).
- G. Darai, M. Handermann et al.: Lexikon der Infektionskrankheiten des Menschen. 3. Auflage. Springer, Heidelberg 2009, ISBN 978-3-540-39005-3.
- S. Vadia, E. Arnett u. a.: The pore-forming toxin listeriolysin O mediates a novel entry pathway of L. monocytogenes into human hepatocytes. In: PLoS Pathogens. Band 7, Nr. 11, November 2011, ISSN 1553-7374, S. e1002356, doi:10.1371/journal.ppat.1002356, PMID 22072970, PMC 3207921 (freier Volltext) – (englisch).
Weblinks
- US FDA / CFSAN Foodborne Pathogenic Microorganisms and Natural Toxins Handbook – Listeria monocytogenes (englisch)
- Listeriose: hochvirulenter Erregerstamm entdeckt, auf scinexx.de vom 10. Oktober 2019
